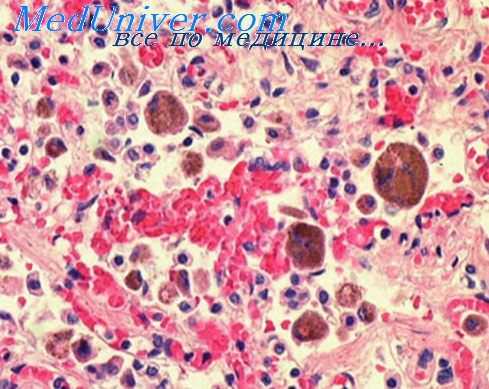

Венозная гиперемия. Ишемия - малокровие тканей и органов
Добавил пользователь Владимир З. Обновлено: 16.01.2026
В настоящей статье подробно разобраны три основных механизма развития артериальной гиперемии: нейрогенный, гуморальный и нейромиопаралитический. Указаны примеры для каждого механизма и отмечены их возможные разновидности. Представлены возможные причины возникновения артериальной гиперемии, а также дана их классификация по происхождению и природе причинного фактора. В статье описаны два вида артериальной гиперемии: физиологическая и патологическая. Дана их более детальная классификация в зависимости от этиологии и патогенеза: рабочая, реактивная, коллатеральная, воспалительная и другие. Отмечены конкретные примеры, возможные последствия и осложнения различных видов артериальной гиперемии. Также акцентируется внимание на основных симптомах и внешних проявлениях и изменениях органов и тканей при гиперемии, которые имеют клиническое значение. Кроме того, в статье разобрано само понятие артериальной гиперемии, а также отмечена ее принадлежность к процессу воспаления и расстройству периферического кровотока. Отдельно заостряется внимание на значении гиперемии в патологии. Сделан вывод о том, что гиперемия может рассматриваться как с точки зрения вредности, так и с точки зрения полезности для организма.
2. Основы патофизиологии. Типовые патологические процессы: учебное пособие / Д.А. Еникеев, Э.Н. Хисамов, Е.А. Нургалеева, Д.В. Срубилин, Г.А. Байбурина, В.И. Лехмус, Г.Г. Халитова, Е.Р. Фаршатова, Л.В. Нагаева, В.П. Головин – Уфа: Изд.-во ФГБОУ ВО БГМУ Минздрава России, 2017 – 164 с.
3. Патологическая анатомия: учебник / А.И. Струков, В.В. Серов. ; под ред. В.С.Паукова. – 6-е изд., перераб. и доп., 2015. – 880 с.: ил.
4. Патофизиология: учебник : в 2 т. / под ред. В.В. Новицкого, Е.Д. Гольдберга, О.И. Уразовой. - 4-е изд., перераб. и доп. - ГЭОТАР-Медиа, 2017 - Т. 1 - 848 с.: ил.
Введение.
Артериальная гиперемия - увеличение кровенаполнения органа или ткани вследствие увеличения притока крови по расширенным артериям и артериолам. Она относится к сосудистым реакциям, которые развиваются в участке воспаления и является одной из основных форм расстройства периферического кровообращения.
Причины артериальной гиперемии
Среди основных причин артериальной гиперемии можно выделить различные факторы, которые можно классифицировать по определенным критериям:
В зависимости от происхождения выделяют:
1) Экзогенные-действуют на ткань или орган извне, вызывая гиперемию; делятся на инфекционные факторы(эндотоксины) и неинфекционные факторы различной этиологии.
2) Эндогенные-образуются в организме (накопление органических кислот, отложение солей и прочее)
По природе причинного фактора:
1) Химические агенты (кислоты, щёлочи)
2) Физические агенты (высокая температура)
3) Биологические агенты (физиологически активные вещества)
Механизмы артериальной гиперемии
Различают 3 основных механизма возникновения артериальной гиперемии:
- нейрогенный
- гуморальный
- нейромиопаралитический
1)Нейрогенный механизм. Подразделяется на 2 вида: нейротонический и нейропаралитический.
Нейротонический механизм отличается тем, что при нем будут особенно ярков наблюдаться эффекты парасимпатических вазодилататорных влияний на сосудистую стенку (при сравнении с симпатическими влияниями). Яркий пример этого механизма-появление гиперемии при испытывании чувства стыда.
Нейропаралитический механизм характеризуется снижением или отсутствием симпатических влияний на стенки артерий/артериол. Яркий пример такого механизма- появление румянца на щеках в холодное время года.
Этот механизм характеризуется действием на артерии, артериолы вазодилататоров (биологически активных веществ с сосудорасширяющим эффектом) при их местном увеличении и заключается в повышении чувствительности рецепторов стенок артериальных сосудов к вазодилататорам. Расширение сосудов вызывают такие вещества как гистамин, брадикинин, молочная кислота, избыток углекислоты, оксида азота и др.
Этот механизм характеризуется истощением запасов катехоламинов в синаптических везикулах и снижением тонуса гладких мышц артериальных сосудов. Это может происходить при длительном воздействии факторов химической и физической природы на органы и ткани (например, при применении грелок или горчичников); при прекращении продолжительного давления на стенки артерий (например, тугого бинта). [1]
Виды артериальной гиперемии
Различают 2 основных вида артериальной гиперемии:
1) Физиологическая делится на:
Рабочая гиперемия. Она будет наблюдаться при увеличении уровня функционирования тканей и органов. К примеру, в мышце при выполнении какой-либо физической нагрузке будет наблюдаться гиперемия при ее сокращении; гиперемия будет наблюдаться в поджелудочной железе и кишечной стенке во время пищеварения. Это примеры гиперемии в усиленно работающих органах, тканях.
Реактивная гиперемия. Она будет наблюдаться после временного прекращения кровотока. Она имеет защитно-приспособительный характер. К примеру, гиперемия в очаге воспаления, вокруг чужеродного трансплантата, вокруг зоны некроза. (То есть будет наблюдаться при включении в работу защитных механизмов)
2) Патологическая артериальная гиперемия
Эта гиперемия никак не связана с изменением функций органа/ткани и носит повреждающий характер. Она сопровождается нарушениями кровоснабжения, микроциркуляции, транскапиллярного обмена. Такая гиперемия будет возникать, например, в области хронического воспаления. Патологическая артериальная гиперемия может быть в головном мозге при гипертоническом кризе. [2]
Патологическую артериальную гиперемию также можно классифицировать в зависимости от патогенеза и этиологии на:
1) Коллатеральная гиперемия. Она возникает в случае внезапного и сильного нарушения нормального тока крови по артериальному стволу, из-за чего кровь устремляется по коллатеральным сосудам, которые отходят от артерии выше места возникновения данного нарушения. При этом коллатеральные сосуды расширяются и переполняются кровью.
2) Ангионевротическая гиперемия. Развивается вследствие паралича сосудосуживающих нервов или раздражения сосудорасширяющих нервов, то есть при нарушении иннервации. Она может возникать на разных участках тела, а также при развитии некоторых инфекционных процессов. Этот вид гиперемии не является особо опасным, так как практически не оставляет последствий и достаточно быстро проходит.
3) Вакантная гиперемия. Она развивается при нарушении барометрического давления, и, чаще всего, наблюдается при кессонных болезнях, а также при использовании медицинских банок, создающих разряженное пространство над участком кожи. Этот вид гиперемии довольно опасен, так как может осложняться возникновением газовой эмболии, кровоизлияниями и тромбозом сосудов.
4) Воспалительная гиперемия. Она наблюдается в поврежденных тканях и является постоянным спутником воспаления.
5) Гиперемия после анемии(постанемическая). Этот вид гиперемии возникает при быстром устранении причины сдавливания артерии. Сосуды ткани, которая ранее была обескровлена, начинают слишком быстро наполняться кровью, в результате чего возникает гиперемия. Однако это может быть опасно из-за возможности кровоизлияния и разрыва сосудов. [3]
Симптомы артериальной гиперемии.
Основные внешние изменения определяются увеличением кровенаполнения органа и интенсивности кровотока в нем.
- увеличение числа и диаметра артериальных сосудов
- изменение окраски органана ало-красный (как правило, из-за того, что поверхностно расположенные сосуды в коже/слизистых наполняются кровью, содержащей большое количество эритроцитов и оксигемоглобина). явление артериализации венозной крови так как в результате ускорения кровотока в капиллярах при артериальной гиперемии кислород используется тканями только частично.
- может изменяться температура поверхностно расположенных тканей/органов: она повышаетсяиз-за усиления кровотока в них.
- тургор (напряжение) тканей тоже будет изменяться: он будет возрастать,так как микрососуды расширяются, переполняются кровью и количество функционирующих капилляров возрастает. (то есть капилляров, по которым протекают плазма и форменные элементы) [4]
Значение артериальной гиперемии.
Артериальная гиперемия может иметь и положительное, и негативное значение для организма человека.
Если артериальная гиперемия способствует соответствию между метаболическими потребностями тканей и интенсивностью микроциркуляции, а также устраняет местные нарушения, то ее влияние на организм можно считать положительным. Если же она не способствует всему этому, то влияние будет отрицательным.
Положительное значение артериальной гиперемии. Оно заключается, прежде всего, в стимуляции доставки кислорода и питательных веществ к различным тканям и в стимуляции удаления продуктов обмена из тканей. При обычных условиях появление этой гиперемии связано с усиленной активностью органов/тканей и интенсивностью обмена веществ. При патологии такая гиперемия также может иметь положительное значение, если она компенсирует какие-то нарушения в организме. К примеру, она может возникать, когда ткань испытывает недостаток в кровоснабжении. То есть если местный кровоток изначально был ослабленным из-за сужения приводящих артерий, то дальше появится постишемическая гиперемия, которая будет иметь положительное значение из-за своей компенсаторной роли: в ткань приносится больше кислорода и питательных веществ, гораздо лучше и быстрее производится удаление продуктов обмена из них (это относится к последствиям ишемии).
Отрицательное значение артериальной гиперемии. Оно наблюдается, когда нет необходимости в усиленном кровотоке или же степень артериальной гиперемии слишком высокая. В подобных ситуациях гиперемия будет наносить организму вред. Например, могут возникать кровоизлияния в ткани из-за разрыва сосудистых стенок при их патологическом изменении при местном повышении давления в микрососудах. Кроме того, при длительной артериальной гиперемии могут создаваться благоприятные условия для выхода токсичных веществ, БАВ из воспалительного очага и их дальнейшего распространения по общему кровотоку. Такие ситуации очень опасны для центральной нервной системы, так как вследствие сильного тока крови в головной мозг, могут возникать головные боли, головокружения и другие неприятные симптомы, которое могут иметь неблагоприятный исход. [1, 5]
Вывод: В целом, можно сделать вывод о том, что артериальная гиперемия не может иметь только положительного или отрицательного влияния на организм. В разных ситуациях этот процесс играет абсолютно разную роль, которая будет заключаться либо в проявлении компенсаторных свойств, помогающих организму в сложных для него условиях, либо в развитии различных патологических состояний и осложнений, приводящих к тяжелым последствиям.
Венозная гиперемия. Ишемия - малокровие тканей и органов
Тромбоз. Изменение лимфообращения
Тромбоз — это процесс прижизненного свертывания крови в просвете кровеносных сосудов, развивающийся при нарушении свертывающей и антисвертывающей систем крови и при нарушении целости сосудистой стенки. Факторы, способствующие его возникновению, многообразны. Известно, чю тромбоз возникает при различных патологических процессах и интоксикациях па фоне измененной реактивности организма. В судебно-гистологических исследованиях данный вид нарушения кровообращения нередко выявляют в случаях переживания (в часах) тяжелой механической травмы, при смерти в послеоперационном периоде по поводу механических и ожоговых травм, при криминальном аборте и скоропостижной смерти от ишемической болезни сердца.
Тромбоз возникает в артериях и, чаще, в венах. Различают тромбы красные, белые и смешанные. Они бывают пристеночные и обтурирующие. Пристеночные тромбы чаще встречаются в крупных артериях и венах, обтурпрующпе — в мелких сосудах
Изменение лимфообращения
Из изменений лимфообращения наибольшее практическое значение в судебной медицине имеют реакция лимфатических узлов и так называемый реактивный или травматический отек.

Реакция лимфатических узлов при травме. При травме возникает в ответ на кровоизлияние в ткани или полости тела. Из очага кровоизлияния форменные элементы крови всасываются через тканевые щели в лимфатические сосуды и с лимфой переносятся в регионарные лимфатические узлы. Последние увеличиваются в размерах и на разрезах приобретают красноватый цвет. При микроскопическом исследовании в них обнаруживают свежие и выщелоченные эритроциты, явления эритрофагии, повышенное кровенаполнение, набухание волокнистых структур и клеток. При размозжении мягких тканей, богатых жировой клетчаткой, в лимфатических узлах можно обнаружить и капли эмульгированного жира.
Появление травматического отека связано с острым местным или регионарным нарушением лимфообращения и характеризуйся увеличенным количеством тканевой жидкости. Травматический отек может быть местным и регионарным. Примером местного отека является отек кожи вокруг ожога пли друюго повреждения, регионарною — отек мягких тканей головы и ягодичной области новорожденного, возникший вследствие родовой травмы. Отечные ткани становятся пастозными, легко рвутся и расслаиваются, с поверхности их стекает прозрачная жидкость. Значительный отек кожи может сопровождаться отслойкой эпидермиса н образованием пузырен При микроскопическом исследовании кожи отмечают стушеванные границы между собственно кожей и подкожной жировой клетчаткой, уплощение и даже исчезновение сосочков, так что граница между эпидермисом и собственно кожей утрачивает характер волнистой линии.
В цитоплазме клеток эпидермиса появляются вакуоли, ядра бледно окрашиваются. В собственно коже отечная жидкость раздвигает и сдавливает клетки и волокнистые структуры Коллагеновые волокна расслаиваются на фибриллы, окрашиваются никрофуксином в желтый цвет, местами с оранжевым оттенком.
Интенсивность отека в других органах и тканях во многом связана с их структурой и свойствами. В органах и тканях, чувствительных к гипоксии в силу гидратации тканей (например, головной мозг), отек, как правило, сочетается с их набуханием.
Информация на сайте подлежит консультации лечащим врачом и не заменяет очной консультации с ним.
См. подробнее в пользовательском соглашении.
Первичные изменения кровообращения. Гиперемия и ее диагностика
В ответ па разнообразные внешние воздействия, приводящие к смерти в различные сроки (до нескольких суток), в тканях п органах возникают изменения крово- и лимфообращения, другие приспособительные реакции, направленные на сохранение гомеостаза, воспаление, а в ряде случаев и некроз. Все эти изменения имеют важное значение для определения прижизненности повреждений, времени наступления и механизма смерти.
Вазомоторные реакции являются первым и немедленным ответом на различные раздражения и повреждения. Их можно подразделить по срокам возникновения на первичные и ранние, а по отношению к зоне воздействия пли очагу повреждения — на местные, регионарные и общие. Первичные изменения, как правило, только сосудистые, а ранние — уже сосудисто-тканевые. Вид, сила воздействия, анатомические особенности покровных тканей п органов обусловливают различие в сроках появления и степени выраженности изменений кровообращения.
Первичные изменения кровообращения возникают во время патогенного воздействия или в ближайшие минуты после него и бывают местными (в очаге повреждения), регионарными (в поврежденном органе или ткани па некотором отдалении от очага повреждения) и общими (в других неповрежденных органах). К ним относят гиперемию (артериальную, венозную), ишемию, изменения реологических свойств крови, эмболию (условно), а также кровоизлияния.
Гиперемия. Артериальная гиперемия (местная и регионарная) возникает в тех случаях, когда в артериальное русло области повреждения поступает увеличенное количество крови. Она часто бывает следствием раздражения сосудорасширяющих или блокирования сосудосуживающих нервов. Такую ангионевротическую или вазомоторную гиперемию наблюдают при механической и термической травмах, при воздействии кислот и щелочей и т. д. Если кровоток по крупным артериям затруднен, то путем поступления через артерио-артернальные анастомозы возникает коллатеральная гиперемия. Общую гиперемию можно наблюдать при быстром попадании человека из области высокого в область низкого или нормального атмосферного давления (так называемая вакатная гиперемия). В этих случаях в сосудистое русло поступает кровь из депо.
Венозная гиперемия встречается при нарушении оттока крови. Во многих случаях она является следствием общего нарушения кровообращения, по может носить и местный, п регионарный характер. Общую венозную гиперемию обычно наблюдают при сердечно-сосудистой недостаточности, при всех видах гипоксии, смерти от отравления алкоголем, охлаждения и т. д. Регионарное венозное полнокровие бывает обусловлено или воспалительным процессом, или перераспределением крови, связанным с механизмом смерти. Местное венозное полнокровие обнаруживают редко, например при закупорке какой-либо вены тромбом.
При всех формах артериальной гиперемии можно наблюдать более или менее выраженное расширение просвета артериальных сосудов н заполнение их кровью. Очертания сосудов бывают правильные: округлые, овальные, вытянутые. Особенно полнокровными оказываются сосуды терминального участка артериального русла: артериолы, прекапилляры, капилляры. Местами они представляются как бы инъецированными. Сегменты сосудистого русла, не функционировавшие до этого, наполняются кровью. Таким образом, увеличивается плотность сосудистой сети на единицу площади, и в гистологических препаратах полнокровные сосуды находят в каждом поле зрения.
Если в сосудах данной области имеются специализированные усройства, то они обеспечивают усиленный приток крови. При целенаправленном исследовании серии срезов можно увидеть, что артерии занимательного типа на месте артерио-артериальных анастомозов открыты, а валики и подушечки растянуты по окружности сосуда и почти не вдаются в просвет.
Венозная гиперемия характеризуется резким расширением и кровенаполнением венозного отрезка терминального сосудистого русла (капилляров, посткапнлляров и венул). Нередко сосуды представляются паретически растянутыми. Однако, оценивая данное состояние, надо помнить, что капилляры с наибольшим диаметром просвета могут относиться к системе магистральных, которые обеспечивают анастомозы между артериолами и венулами в обход конечного отрезка сосудистой сети (артериальный капилляр — венозный капилляр) и, таким образом, не служат проявлением гиперемии. В мелких сосудах подкожной клетчатки конечностей, в клетчатке, окружающей эндокринные органы и сосудисто-нервные пучки в области шеи, при венозной гиперемии часто находят устьевые клапаны в недостаточно разомкнутом состоянии. В более крупных сосудах бывают отчетливо выражены мышечные валики.
В связи с тем, что по механизму возникновения венозная гиперемия, в отличие от артериальной, является более продолжительной, в органах и тканях обнаруживают и другие изменения. Так, в коже на фоне резкого расширения и переполнения кровью вен собственно кожи и подкожной клетчатки наблюдают отек и расширение лимфатических сосудов. Во внутренних органах также возникает отек; наблюдается различная степень атрофии паренхимы, а при хроническом венозном застое и склероз стромы.
Ишемия (малокровие) может быть местной, регионарной и общей. Местное или регионарное малокровие возникает в тех случаях, когда приток крови к органу пли ткапп уменьшен либо вовсе прекращен, а отток крови не нарушен. Причинами служат спазм артерии, их сдавленно, закрытие просвета. В связи с этим различают ангиоспастическое, так называемое компрессионное и обтурационное малокровие. Эти виды малокровия наблюдают при самых различных внешних воздействиях и интоксикациях некоторыми ядовитыми веществами, обладающими сосудосуживающим и тромбообразующпм действием. При механической травме могут иметь место все три механизма ишемии.
Общее малокровие органов п тканей может развиваться при большой потере крови, например в связи с ранением магистральных сосудов.

При малокровии кровенаполнение одних сосудов умеренное, других — слабое. Многие артериолы и капилляры спавшиеся, имеют вид клеточных тяжей. По отношению к просвету сосуда эластические волокна выглядят складчатыми, а по опюшению к толще стенки они сближены друг с другом, образуют сплошной эластический пояс. Очертания сосудов бывают причудливые. Ядра эндотелия па дне бухт набухшие, нередко располагаются в виде частокола, а на вершине складок уплощены и гиперхромыы. Такие картины наиболее демонстративны в сосудах, расположенных в рыхлой ткапп, например: в подкожной и паранефральной клетчатке, а также в междольковой ткани легких, в мягких мозговых оболочках. В некоторых случаях может даже наблюдаться «ущемление» глакомышечных клеток между эластическими мембранами.
Спазм возникает не только в артериальной, но и в венозной системе. Активная роль венозных сосудов в реакции на травму нашла подтверждение в данных физиологии, показавших, что реакция венозного тонуса на внешние раздражители в общем аналогична реакции артериального тонуса и имеет рефлекторный характер. Тонус вен непрерывно регулируется нервными влияниями. Подобно артериям они реагируют на сосудистые яды. На гистологических препаратах оценка спастического состояния вен затруднительна.
Синхронно с артериальными и венозными сосудами обычного типа реагируют и сосуды с приспособительными устройствами. Так, артерии запирательного типа большей частью оказываются закрытыми, а мышечные валики, артериальные подушечки и почки— набухшими, заметно уменьшающими сосудистый просвет. Однако в ряде случаев наряду с таким состоянием специализированных сосудов в том же органе могут быть сосуды и с широко раскрытым просветом.
Сухая гангрена - симптомы и лечение
Что такое сухая гангрена? Причины возникновения, диагностику и методы лечения разберем в статье доктора Манасяна К.В., сосудистого хирурга со стажем в 10 лет.
Над статьей доктора Манасяна К.В. работали литературный редактор Маргарита Тихонова , научный редактор Сергей Федосов
Определение болезни. Причины заболевания
Гангрена — это некроз (омертвление) тканей живого организма, связанных с внешней средой, например, кожи, лёгких, кишечника и других. С древнегреческого данный термин переводится как "разъедающая язва".
Сухая гангрена — это опасное заболевание, требующее незамедлительного лечения. При этой патологии отмирание ткани происходит без выраженного инфекционного и воспалительного процесса. Иначе такой характер течения заболевания называют мумификацией, т. е. отсыханием органа.

Механизмы возникновения гангрены бывают двух типов:
- прямыми (травматическими и токсическими) — появляются по причине непосредственного повреждения, иногда даже незначительного;
- непрямыми (ишемическими, аллергическими, трофоневрологическими) — происходит опосредованное отмирание тканей через анатомические каналы, в частности, при поражении сосудистой системы.
Исходя из этого факторы риска развития сухой гангрены можно также разделить на две группы:
- Внешние (экзогенные):
- переохлаждение (обмоорожение);
- химический ожог;
- удар током высокого напряжения.
- Внутренние (эндогенные): артерий нижних конечностей; ;
- курение;
- воспалительные заболевания артерий (васкулиты, в частности тромбангиит). [4][5][6]
Зачастую гангрена возникает при совокупности факторов, например, в результате механического повреждения кожи пациента с сахарным диабетом. По статистике, доля людей с мумификацией, развившейся на фоне подобных факторов и приведшей к ампутации конечности, составляет 4,2-6,4 на одну тысячу человек в год. В связи с этим люди с диабетической стопой относятся к группе риска развития гангрены. [10]
При обнаружении схожих симптомов проконсультируйтесь у врача. Не занимайтесь самолечением - это опасно для вашего здоровья!
Симптомы сухой гангрены
К симптомам сухой гангрены относятся:
- потемнение кожного покрова (вначале кожа бледнеет, приобретает синюшный оттенок, затем постепенно становится чёрной);

- уменьшение кожи в объёме, её высыхание, сморщивание и уплотнение;
- отслаивание эпидермального слоя кожи;
- снижение температуры конечности (зависимость от температуры окружающей среды);
- снижение чувствительности поражённых тканей (онемение);
- наличие специфического запаха отмирающего участка (хоть и не столь сильного);
- ощущение боли (простреливающие, жгучие и ноющие болевые ощущения, которые могут носить постоянный характер, а также усиливаться при минимальной нагрузке);
- покалывание, жжение или зуд в области поражения;
- нарушение функционирования конечности.
Болевой синдром отражает то, насколько сильно страдают окружающие ткани: чем сильнее боль в зоне некроза, тем больше в этой области живых клеток. Ослабление болезненных ощущений или их исчезновение указывает на прогрессирование заболевания, так как чувствительность отмирающей ткани пропадает в результате гибели нервных окончаний. В это время анатомические области, граничащие с сухой гангреной, остро нуждаются в артериальном кровотоке, которого им не хватает. В итоге в этих тканях вырабатываются продукты метаболизма и болевые импульсы.
Сухая гангрена начинается с появления небольшого очага на конечности (как правило, расположенного на пальце). Далее она распространяется на прилегающие пальцы, подошвенную и тыльную поверхность стопы, захватывая всё больше тканей конечности.

Изменения цвета отмирающих участков кожи связано с накоплением в них гемоглобина и выделением эритроцитарного железа, которое в результате соединения с сероводородом воздуха превращается в сульфид железа.
Зона, которая находится на границе гангрены и здоровой ткани называется демаркацией. Обычно она не оформлена. В исключительно редких случаях при естественном течении болезни она может самостоятельно ограничиться, что приведёт к самоампутации отмирающей конечности. [3] [5] [6]

К первым признакам сухой гангрены относятся следующие состояния:
- замерзание конечности даже в тепле;
- боль в ногах и утомляемость после длительной ходьбы;
- наличие долго не заживающих ран и язв на коже конечности.
ВАЖНО: Возникновение одного из этих проявлений при наличии таких предрасполагающих факторов, как сахарный диабет или атеросклероз, — веский повод для скорейшего обращения к врачу-флебологу или хирургу. Промедление как минимум может обернуться для пациента утратой конечности.
Патогенез сухой гангрены
Процесс возникновения и развития сухой гангрены конечностей можно условно разделить на семь этапов:

При естественном течении сухой гангрены признаков инфекции не наблюдается (в отличие от влажной гангрены), однако в омертвевших тканях не исключено наличие возбудителей условно-патогенной инфекции. При этом в зонах некроза не происходит бурного развития инфекции.
Процесс развития сухой гангрены ног и рук может длится от нескольких дней до нескольких месяцев в зависимости от уровня поражения артерий и компенсаторных механизмов саморегуляции. [3] [4] [5] [6] Если некроз уже развился, то заживление без удаления некоторой части конечности невозможно.
Классификация и стадии развития сухой гангрены
В зависимости от распространения некроза на конечности можно выделить следующие виды заболевания:
- гангрена пальцев;
- гангрена дистального сегмента стопы (кисти);
- гангрена пяточной области;
- тотальная гангрена стопы (кисти) или голени (предплечья);
- гангрена бедра (встречается крайне редко, так как пациенты просто не доживают до столь массивного гангренозного поражения). [3][5][6]

По механизму развития различают два вида гангрены:
- Первичная гангрена — это некроз, развившийся в результате ишемии тканей. Иначе говоря, она связана с нарушением проходимости артериального сосуда, кровоснабжающего определённый участок организма.
- Вторичная гангрена — это некроз тканей, возникающий в результате острого гнойного воспаления клетчаточных пространств и фасциальных футляров. Чаще всего развивается при флегмоне стопы, затрагивая пальцы, а также при или глубоком абсцессе на фоне нейроптической формы синдрома сахарного диабета.
По распространённости выделяют три степени гангрены:
- поверхностную — поражается лишь дерма;
- глубокую — проникает в сухожилия, полости суставов, фасции и кости;
- тотальную — затрагивает все отделы органа или конечности.
Помимо сухой гангрены существует ещё влажная и газовая.
Влажная гангрена протекает с преобладанием инфекционного компонента, т. е. гнилостного расплавления. В процесс вовлекаются все без исключения ткани — кожа, подкожно-жировая клетчатка, фасции, связки, мышцы, сухожилия и кости. Кожные покровы местами приобретают багрово-синюшный, чёрный или серо-зелёный цвет. Характерно появление эпидермальный пузырей, наполненных вначале бурым, а затем зеленоватым содержимым с выраженным неприятным гнилостным запахом.
В отличие от сухой гангрены при влажной ткани не уплотняются, а распадаются, становятся рыхлыми и разжижаются. Отёк и гиперемия кожи быстро распространяются. Кожа голени может быть напряжена, лосниться. Без активного лечения демаркационная линия не появляется, так как процесс стремится к генерализации.

Газовая гангрена отличается возникновением вокруг очага некроза лёгкой крепитации газа под кожей, т. е. ощущением хруста, которое появляется из-за лопающихся пузырьков газа в тканях. Крепитация не слышна, но осязается пальцами как "скрип" крахмала или снега под ногами. Объективно газ в мягких тканях может быть обнаружен при рентгенографии конечности на достаточно "мягких" снимках. [11]
Осложнения сухой гангрены
Само по себе наличие гангрены указывает на полную нежизнеспособность и омертвление тканей, предполагая крайнюю степень патологического процесса. Поэтому отсутствие своевременного лечения может привести к потере поражённой конечности.
Сухая гангрена не может перерасти во влажную или газовую гангрену, как ошибочно утверждают многие источники, потому что изначально при возникновении некроза становится очевиден механизм развития гангрены. [1] [2] [3] [4] [7]
Редкими осложнениями сухой гангрены являются сепсис и септический шок. Они возникают в связи с токсическим действием продуктов распада при проникновении их в системный кровоток. Данные осложнения способны привести к полиорганной недостаточности и, как следствие, летальному исходу.
К проявлениям сепсиса относятся:
- ознобы;
- высокая или очень низкая температура тела (больше 38°C или меньше 36°C);
- одышка (частота дыхания более 20 в минуту);
- артериальная гипотензия (пульс более 90 ударов в минуту);
- аритмия;
- олигурия (объём мочи менее 0,5 мл/кг/ч);
- вялость, заторможенность;
- наличие различных лабораторные показания, не поддающаяся коррекции — низкий уровень белка, тромбоцитов и красных кровяных телец, а также высокий уровень билирубина, остаточного азота, мочевины, сахара в крови и ацетона в моче.
В случае септического шока давление становится крайне низким, даже на фоне интенсивного вливания внутривенных растворов. В связи с этим около 30-40 % пациентов умирает несмотря на оказываемое лечение. [12]
Диагностика сухой гангрены
Диагностика сухой гангрены достаточно проста, так как на некроз указывает внешний вид поражённого органа:
- его сухость;
- уменьшение участка кожи в объёме;
- тёмный, вплоть до чёрного, цвет кожи;
- наличие слабого неприятного запаха и болей непосредственно в мёртвом участке;
- наличие прохладных на ощупь окружающих тканей с выраженным болевым синдромом в них. [1][2][3][4][7]
При осмотре необходимо диагностировать причину сухой гангрены (например, атеросклероз артерий и тромбангиит). Для этого нужно проверить пульсацию артерий как поражённой, так и здоровой ноги на уровне паховых и подколенных областей, позади медиальной лодыжки и на тыле стопы. В дальнейшем необходимо подтвердить причинный диагноз с помощью ультразвукового исследования.

В качестве предоперационной подготовки для определения вида оперативного лечения выполняется ангиография нижних конечностей:
- при протяжённых поражениях артерий выполняется хирургическая операция — аутовенозное шунтирование;
- при коротких поражениях более предпочтительно выполнить эндоваскулярную операцию (наименее травматичное лечение). [1][2]
Для предоперационной подготовки нужно сдавать общий и биохимический анализ крови, а также бактериальный посев. Эти лабораторные исследования помогут выяснить, не является ли причиной сухой гангрены сахарный диабет.
Лечение сухой гангрены
С целью предотвращения гангрены и максимально возможного сохранения конечности требуется восстановить кровоток в тканях, окружающих гангренозный участок.
Нормализовать кровообращение в органе можно при помощи оперативного вмешательства:
- Реконструктивные операции на артериях конечности (как правило, руки):
- аутовенозное шунтирование;
- эндартерэктомия (удаление закупорки артерии) с аутовенозной пластикой;
- шунтирование артерий аорто-подвздошно-бедренного сегмента синтетичсекими протезами.
- Рентгенэндоваскулярные операции (не показаны пациентам с тромбангиитом):
- стентирование;
- баллонная ангиопластика артерий.


Паллиативные операции (поясничная симпатэктомия и остеотрепанация), проводящиеся для улучшения качества жизни, и другие нехирургические методы лечения (генная и физиотерапия) не способны предотвратить прогрессирование сухой гангрены.
Саму гангренозную ткань необходимо убрать. Для этого проводят:
- малые ампутации — удаление пальцев или части стопы с некрозом;
- некрэктомию — поверхностное удаление некротического струпа до пределов тканей с удовлетворительным кровотоком.
В случаях обширного гангренозного поражения с потерей опороспособной стопы прибегают к ампутации голени либо бедра. Чтобы избежать подобного печального исхода, важно при первых же признаках гангрены без промедления обратиться к врачу: потерять конечность куда страшнее, чем её лечить. Особенно это относится к людям с сахарным диабетом и атеросклерозом: нельзя ждать, когда гангрена начнёт прогрессировать, иначе удаление поражённой конечности будет неизбежным.
Если всё же обширная гангрена стопы привела к потере её опороспособности, то в таких случаях целесообразно выполнение ампутации голени на уровне границы средней и верхней трети. В дальнейшем это позволит подобрать и использовать удобный протез.
Даже после ампутации гангрены, возникшей из-за закупорки артерий ноги, необходимо выполнить реконструктивную (шунтирующую) или рентгенэндоваскулярную операцию на артериях нижней конечности. Делается это с целью обеспечения кровотока для успешного заживления постампутационной культи голени.
При физических причинах гангрены (отморожение) или химических (внутриартериальное введение синтетичсеких наркотиков) лечение заключается в нормализации вязкости крови. Для этого проводится:
- антикоагулянтная и инфузионная терапия;
- профилактика синдрома полиорганной недостаточности;
- хирургическое удаление участка, поражённого сухой гангреной. [1][2][3]
Прогноз. Профилактика
Прогноз зависит от степени гангренозного поражения:
- при гангрене пальцев или небольших участков стопы конечность можно восстановить при реставрации кровотока, удалении омертвевших тканей и создании благоприятных условий для заживления;
- при тотальной сухой гангрене стопы показана ампутация на уровне голени, но с условием, что кровоток в голени достаточен для заживления постампутационной культи;
- при обширной гангрене голени пациенту показана ампутация ноги на уровне бедра.
Пятилетняя выживаемость при сухой гангрене сравнима с выживаемостью при злокачественных новообразованиях (например, раковой опухолью кишечника): к концу первого года после подтверждения диагноза "Критическая ишемия" (критическое снижение кровоснабжения) лишь 45 % пациентов имеют шанс сохранения конечности, а около 30 % продолжают жить после ампутации бедра или голени, а 25 % — умирают.
Тем не менее число больших ампутаций остаётся высоким, а их исходы — крайне тяжёлыми. Риск смертности в течение 30 дней после таких ампутаций составляет 4-30 %, а риск развития осложнений, таких как инфаркт миокарда, инсульт, инфекция, — 20-37 %. [1] [7] [10]
Реабилитация и протезирование
Трудности в реабилитации пациентов после ампутаций и протезирования у многих пожилых пациентов отрицательно влияют на отдалённые результаты и качество их жизни.
Период реабилитации зависит от объёма гангренозного поражения, качества заживления дефекта, сопутствующих соматических заболеваний, возраста пациента и его желания вернуться к полноценной жизни. Как правило, при успешном лечении и соблюдении всех рекомендаций врача длительность реабилитации составляет 3-6 месяцев.
На качество реабилитации также влияет питание. Поэтому в период восстановления рацион должен состоять из белковой и калорийной (но не жирной) пищи: из мяса индейки, рыбы, фасоли, творога и яиц. От жирной пищи во время реабилитации лучше отказаться.
Первичный протез подбирается после заживления раны культи. Затем, когда сформирована мышца культи, пациенту подбирают вторичный протез. Этим занимается врач-реабилитолог совместно с протезистом. [7] [8] [9]
Профилактика
Для предупреждения развития гангрены у предрасположенных к этому людей (например, лиц с сахарным диабетом, атеросклерозом), важно соблюдать меры профилактики:
- отказ от курения — эта пагубная привычка может привести к ухудшению кровообращения и закупорке сосудов;
- контроль уровня сахара в крови;
- проверка тела на наличие повреждений, их лечение и ежедневное наблюдение за их заживлением;
- незлоупотребление алкоголем.
Также для профилактики гангрены нужно избегать обморожений и иных внешних причин образования некроза.
Читайте также:
